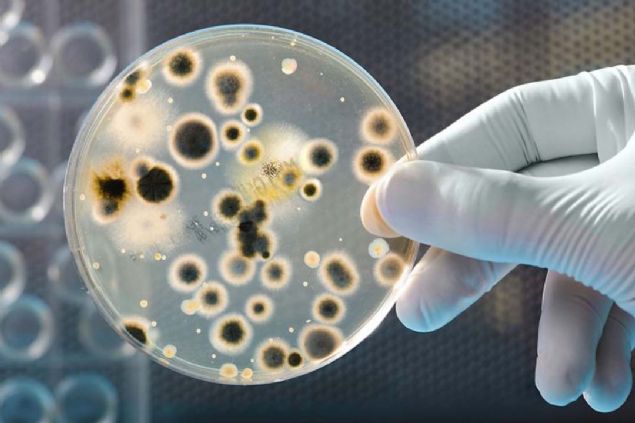

İSTANBUL 32°C / 21°C
- Adana
- Adıyaman
- Afyon
- Ağrı
- Aksaray
- Amasya
- Ankara
- Antalya
- Ardahan
- Artvin
- Aydın
- Balıkesir
- Bartın
- Batman
- Bayburt
- Bilecik
- Bingöl
- Bitlis
- Bolu
- Burdur
- Bursa
- Çanakkale
- Çankırı
- Çorum
- Denizli
- Diyarbakır
- Düzce
- Edirne
- Elazığ
- Erzincan
- Erzurum
- Eskişehir
- Gaziantep
- Giresun
- Gümüşhane
- Hakkari
- Hatay
- Iğdır
- Isparta
- İstanbul
- İzmir
- K.Maraş
- Karabük
- Karaman
- Kars
- Kastamonu
- Kayseri
- Kırıkkale
- Kırklareli
- Kırşehir
- Kilis
- Kocaeli
- Konya
- Kütahya
- Malatya
- Manisa
- Mardin
- Mersin
- Muğla
- Muş
- Nevşehir
- Niğde
- Ordu
- Osmaniye
- Rize
- Sakarya
- Samsun
- Siirt
- Sinop
- Sivas
- Şanlıurfa
- Şırnak
- Tekirdağ
- Tokat
- Trabzon
- Tunceli
- Uşak
- Van
- Yalova
- Yozgat
- Zonguldak
Parçalı bulutlu, güneşli
Gece modu
Gündüz modu
İSTANBUL00:00
- Adana
- Adıyaman
- Afyonkarahisar
- Ağrı
- Aksaray
- Amasya
- Ankara
- Antalya
- Ardahan
- Artvin
- Aydın
- Balıkesir
- Bartın
- Batman
- Bayburt
- Bilecik
- Bingöl
- Bitlis
- Bolu
- Burdur
- Bursa
- Çanakkale
- Çankırı
- Çorum
- Denizli
- Diyarbakır
- Düzce
- Edirne
- Elazığ
- Erzincan
- Erzurum
- Eskişehir
- Gaziantep
- Giresun
- Gümüşhane
- Hakkari
- Hatay
- Iğdır
- Isparta
- İstanbul
- İzmir
- Kahramanmaraş
- Karabük
- Karaman
- Kars
- Kastamonu
- Kayseri
- Kırıkkale
- Kırklareli
- Kırşehir
- Kilis
- Kocaeli
- Konya
- Kütahya
- Malatya
- Manisa
- Mardin
- Mersin
- Muğla
- Muş
- Nevşehir
- Niğde
- Ordu
- Osmaniye
- Rize
- Sakarya
- Samsun
- Siirt
- Sinop
- Sivas
- Şanlıurfa
- Şırnak
- Tekirdağ
- Tokat
- Trabzon
- Tunceli
- Uşak
- Van
- Yalova
- Yozgat
- Zonguldak
kalan süre
Petrol yiyen bakteri bulundu

17 Nisan 2019 Çarşamba
Bilim insanları, Pasifik Okyanusunun batısında yer alan Mariana Çukurunun dibinde petrol yiyen nadir bir bakteri türü keşfetti.

1
/
9
Bilim insanları, Pasifik Okyanusu'nun batısında yer alan Mariana Çukuru'nun dibinde petrol yiyen nadir bir bakteri türü keşfetti.

2
/
9
Çukur, 2 bin 550 km uzunluğunda. Derinliğiyse neredeyse 11 bin metreye ulaşıyor.

3
/
9
Petrol sızıntılarıyla mücadele konusunda faydalı olabilecek benzer bakteri türleri daha önce de bulunmuştu.

4
/
9

5
/
9
Ancak bu yeni keşif, söz konusu türdeki çok sayıda bakterinin bölgede kümelendiğini gösteriyor.

6
/
9
7
/
9

8
/
9

9
/
9
